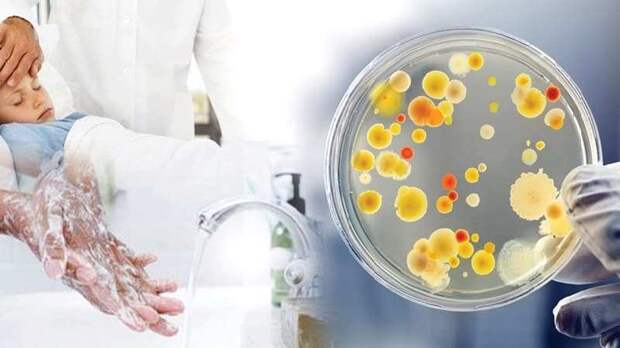

По предварительным данным, у школьников подмосковного Красноармейска обнаружены признаки ротавирусной инфекции. Родители детей обратились к врачам в связи с недомоганием школьников общеобразовательных учреждений № 3 и № 4. Источник ТАСС в правоохранительных органах сообщил, что «предварительно, причиной отравления стал ротавирус», так как некоторые родители детей также обратились к медикам с недомоганием, при этом школьную еду не употребляли.

Свежие комментарии